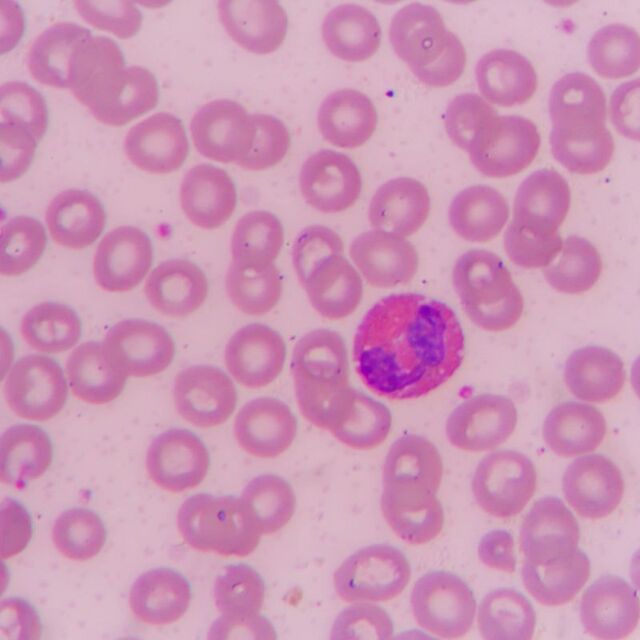

Digital Edition
Subscribe
Get an all ACCESS PASS to the News and your Digital Edition with an online subscription
Call for more care
A LIMESTONE Coast local is calling for better compassion and better staffing at a local hospital.
Nichole King has started an online petition, calling for...